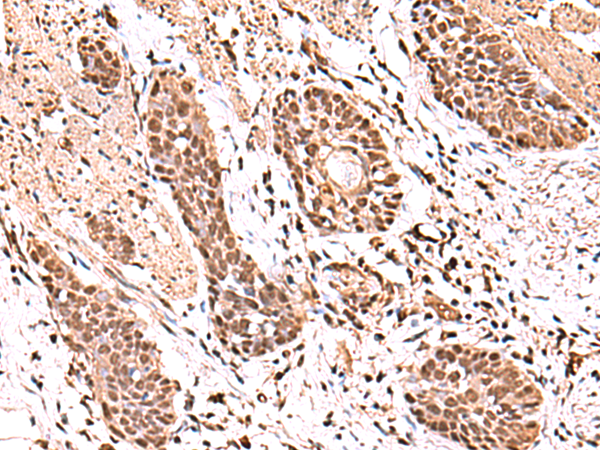

中文名稱: 兔抗ACTL6B多克隆抗體
|
Background: |
The protein encoded by this gene is a member of a family of actin-related proteins (ARPs) which share significant amino acid sequence identity to conventional actins. Both actins and ARPs have an actin fold, which is an ATP-binding cleft, as a common feature. The ARPs are involved in diverse cellular processes, including vesicular transport, spindle orientation, nuclear migration and chromatin remodeling. This gene encodes a subunit of the BAF (BRG1/brm-associated factor) complex in mammals, which is functionally related to SWI/SNF complex in S. cerevisiae and Drosophila; the latter is thought to facilitate transcriptional activation of specific genes by antagonizing chromatin-mediated transcriptional repression. This subunit may be involved in the regulation of genes by structural modulation of their chromatin, specifically in the brain. Alternative splicing results in multiple transcript variants. |
|
Applications: |
ELISA, WB, IHC |
|
Name of antibody: |
ACTL6B |
|
Immunogen: |
Fusion protein of human ACTL6B |
|
Full name: |
actin like 6B |
|
Synonyms: |
ACTL6; BAF53B; arpNalpha |
|
SwissProt: |
O94805 |
|
ELISA Recommended dilution: |
5000-10000 |
|
IHC positive control: |
Human esophagus cancer |
|
IHC Recommend dilution: |
50-300 |
|
WB Predicted band size: |
47 kDa |
|
WB Positive control: |
HepG2, HL60 and K562 cell lysates |
|
WB Recommended dilution: |
1000-5000 |

購物車
購物車 幫助
幫助
 021-54845833/15800441009
021-54845833/15800441009
